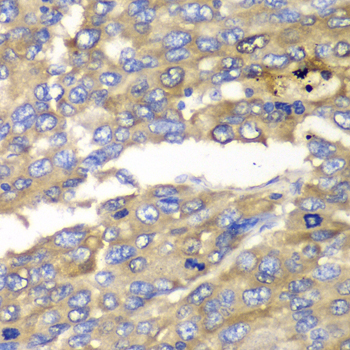

For quotations, please use our online quotation form, and you may also contact us by
service@kendallscientific.com
+1-888.733.6849 (Toll-free)
+1-617.299.7367 (Int’l))
+1-888.733.6849
Our customer service representatives are available 24 hours, Monday through Friday to assist you.| Reactivity | Human Mouse Rat |
| Tested applications | WB IHC |
| Recommended Dilution | WB 1:500 - 1:2000 IHC 1:50 - 1:200 |
| Calculated MW | 33kDa |
| Observed MW | Refer to Figures |
| Immunogen | Recombinant protein of human SLC25A4 |
| Storage Buffer | Store at -20℃. Avoid freeze / thaw cycles. Buffer: PBS with 0.02% sodium azide, 50% glycerol, pH7.3. |
| Concentration | hi |
| Synonym | T1; ANT; AAC1; ANT1; PEO2; PEO3; ANT 1; |

Western blot analysis of extracts of various cell lines, using SLC25A4 antibody.

Immunohistochemistry of paraffin-embedded rat heart using SLC25A4 antibody at dilution of 1:100 (40x lens).
Immunohistochemistry of paraffin-embedded human liver cancer using SLC25A4 antibody at dilution of 1:100 (40x lens).

Immunohistochemistry of paraffin-embedded human esophageal cancer using SLC25A4 antibody at dilution of 1:100 (40x lens).
This gene is a member of the mitochondrial carrier subfamily of solute carrier protein genes. The product of this gene functions as a gated pore that translocates ADP from the cytoplasm into the mitochondrial matrix and ATP from the mitochondrial matrix into the cytoplasm. The protein forms a homodimer embedded in the inner mitochondria membrane. Mutations in this gene have been shown to result in autosomal dominant progressive external opthalmoplegia and familial hypertrophic cardiomyopathy.
N/A